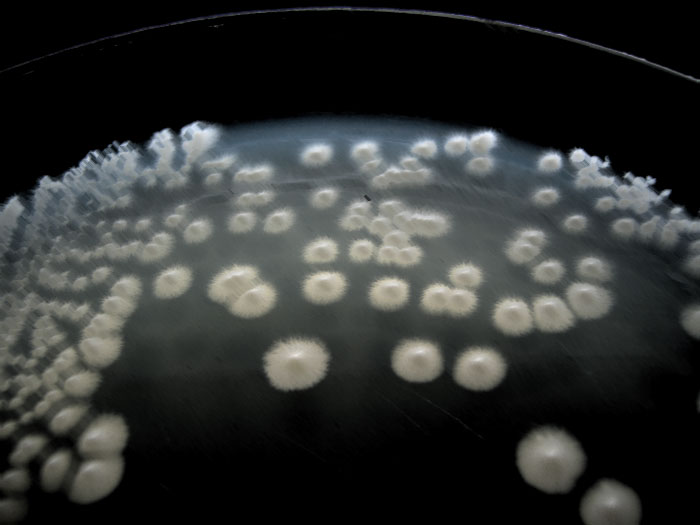

андидоз Влагалища Фото
Кандидоз Влагалища Фото 112 фото
Дизайн Прямоугольной Ванной Комнаты Фото
Блин С Маслом Фото
Приятных Выходных Картинки Женщине
Миникухни Для Дома Недорого Фото И Цены
Порно Фото Абсолютно Голых
Белая Смородина Фото Сорта
Голые Девушки Из Дома 2 Новые Фото
Фото Голы София
Фото Голых Баб Блондинок
Показать Фото Семьи